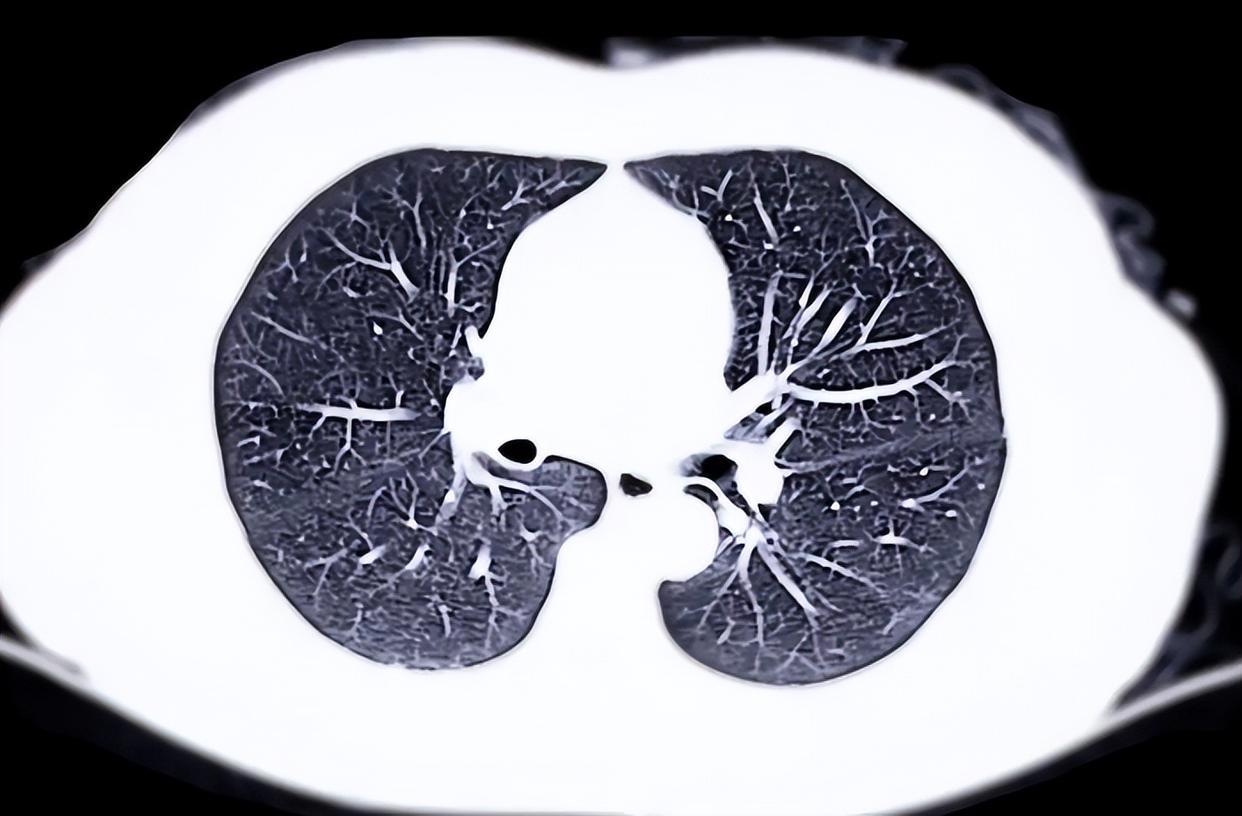

一次看似普通的咳嗽、一阵轻微的胸闷,甚至只是体检时一张“有点异常”的肺部CT,背后可能藏着比感冒更值得警惕的信号?

很多人以为只有吸烟才会伤肺,但临床观察发现,不少从不碰烟的人,肺部影像也出现了令人担忧的变化。这究竟是为什么?难道我们的呼吸,真的正在被看不见的东西悄悄侵蚀?
肺就像一台精密的空气过滤器,每天要处理上万升空气。它没有痛觉神经,一旦出问题,往往“沉默”到晚期才显现症状。
而肺部CT报告中的某些描述,比如“磨玻璃影”“微小结节”“间质性改变”,对普通人来说如同天书,却可能是医生判断肺健康的重要线索。这些术语到底意味着什么?是不是一看到就得立刻紧张?
先别慌。医学界普遍认为,多数肺部微小结节是良性的,尤其直径小于6毫米的,随访观察即可。真正需要关注的是那些形态不规则、边界模糊、或短期内快速增大的病灶。
某三甲医院呼吸科医生曾提醒:“我们不怕发现结节,怕的是忽视变化。”可问题来了——既然很多结节无害,那我们该如何分辨哪些需要干预,哪些只需安心等待?
这就得从肺的“工作环境”说起。除了吸烟,长期暴露于厨房油烟、粉尘、霉菌或空气污染中,都可能让肺泡表面覆盖一层“隐形负担”。中医讲“肺为娇脏,喜润恶燥”,意思是肺最怕干燥、浊气侵袭。
现代研究也证实,PM2.5等细颗粒物能深入肺泡,引发慢性炎症反应。这种低度、持续的刺激,日积月累,就可能在CT上留下痕迹。是不是只要远离污染,肺就能高枕无忧?
未必。个体差异在这里扮演了关键角色。同样的环境,有人安然无恙,有人却早早出现异常。中医体质学说将人分为九种类型,其中“气虚质”“痰湿质”的人群,肺功能相对较弱,更容易受外邪侵扰。
西医则从免疫调节、基因易感性角度解释这一现象。也就是说,肺的“抗压能力”不仅看外部环境,更取决于你自身的底子。可底子差的人,就注定逃不过肺部问题吗?

当然不是。生活方式的微调,往往能带来显著改善。春季气候多变,忽冷忽热,正是呼吸道疾病高发期。此时若贪凉饮冷、熬夜过度,会进一步耗伤肺气。
中医建议此时宜“省酸增甘以养脾气”,因为脾为生痰之源,肺为贮痰之器,健脾有助于减少痰湿内生。而西医则强调充足睡眠、均衡营养对维持呼吸道黏膜屏障的重要性。两者看似路径不同,实则殊途同归——都在强调“整体调养”。
具体该怎么做?保持室内空气流通至关重要。尤其在使用燃气灶、煎炸食物时,务必开启抽油烟机,并开窗通风。研究显示,中式烹饪产生的高温油烟中含有多种醛类和多环芳烃,长期吸入可能损伤肺泡上皮。

适度运动能增强肺活量,比如快走、八段锦、太极拳,都是温和有效的选择。但要注意——运动并非越多越好,过度剧烈反而可能诱发气道痉挛,尤其对已有基础肺病者。
饮食方面,润肺食材值得纳入日常。如梨、百合、银耳、山药等,在中医看来有滋阴润燥之效;现代营养学也认可它们富含多糖、维生素C等抗氧化成分,有助于减轻氧化应激。
但需提醒:食疗不能替代治疗,若已出现持续干咳、活动后气短、夜间盗汗等症状,应及时就医,而非仅靠“喝点梨水”自我安慰。肺的问题,有时藏得太深。

说到就医,很多人一听到“做CT”就害怕辐射。低剂量肺部CT的辐射量极低,相当于乘坐几小时飞机所受的自然本底辐射。对于40岁以上、有吸烟史、家族肺癌史或长期接触有害环境的人群,定期筛查反而是一种保护。
关键在于“合理使用”——既不过度检查造成焦虑,也不因恐惧而延误发现。可如何判断自己是否属于高风险人群?
这里有个简单参考:如果你年龄超过40岁,且符合以下任意一条——吸烟≥20包年(即每天1包吸20年)、长期处于二手烟或职业粉尘环境、有慢性阻塞性肺病(COPD)或肺结核病史、直系亲属患过肺癌。

那么建议咨询专业医生是否需定期肺部筛查。但即便不属于高危,若体检发现异常描述,也应遵医嘱随访。随访不是“等它变坏”,而是动态观察,把握最佳干预窗口。
最后要强调的是,肺的修复能力远超想象。戒烟一年后,纤毛功能开始恢复;改善空气质量后,炎症指标可逐渐下降。中医所说的“扶正祛邪”,正是通过提升自身正气来驱逐病邪。
这意味着,无论你现在肺的状态如何,只要从今天开始调整,都不算晚。真正的健康,不是追求“零风险”,而是建立一种可持续的、与身体对话的生活方式。

当我们不再把肺当成沉默的器官,而是学会倾听它的细微信号——一次久咳不止、一份异常报告、一段莫名乏力——或许就是改变的开始。
健康不是一场冲刺,而是一生的细水长流。愿每个人的肺部CT报告,永远干净如初;更愿我们懂得,在每一次呼吸之间,珍惜这份无声的馈赠。
声明:文中分享的健康知识均源自权威医学资料与专业领域共识,为便于理解部分场景和故事情节进行了虚构加工。本文仅为健康科普分享,不涉及任何医疗指导、诊断建议或用药推荐。内容仅供参考,如果您身体出现不适,请一定要找专业医生咨询。参考文献:[1]中华医学会呼吸病学分会.肺结节诊治中国专家共识(2023年版)[J].中华结核和呼吸杂志,2023,46(3):213-223.[2]国家中医药管理局.中医体质分类与判定标准(修订版)[M].北京:中国中医药出版社,2021.[3]王辰,陈荣昌.呼吸病学(第3版)[M].北京:人民卫生出版社,2022.
#立春养生牢记这几点#
长红配资提示:文章来自网络,不代表本站观点。